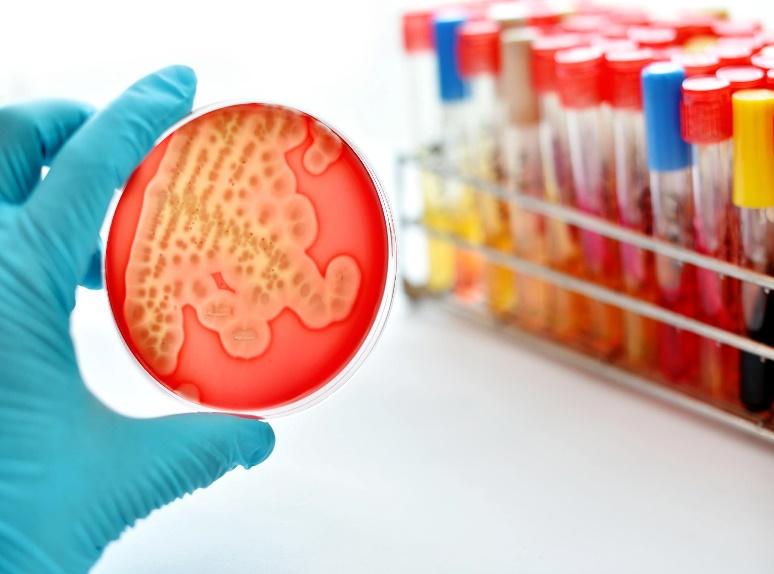

作者:王超群 青岛大学附属泰安市中心医院
审核:张 欣 山东大学齐鲁医院 主任技师
在医院就诊时,如果医生怀疑患者存在感染,往往会开具一系列的感染指标检查。面对这些看似复杂的检查项目和高昂的费用,患者可能会产生疑问:为什么需要查这么多的感染指标?只查一种指标不行吗?本文将从医学专业的角度,对这些问题进行解答和科普。

图1 版权图片 不授权转载
一、感染指标检测的重要性
在医学领域,感染指标检测是诊断感染性疾病的重要手段。通过检测患者体内的各种生物标志物和病原体,医生能够更准确地判断患者是否存在感染,以及感染的类型和程度。这对于制定治疗方案、评估治疗效果和预测病情发展具有重要意义。
首先,感染指标检测可以帮助医生明确感染的类型。感染性疾病种类繁多,包括细菌感染、病毒感染、真菌感染等。不同的病原体需要采用不同的治疗方法。通过检测病原体的特异性抗体、抗原或核酸,医生可以明确感染类型,为患者提供有针对性的治疗。

图2 版权图片 不授权转载
其次,感染指标检测可以评估感染的严重程度。一些生物标志物,如白细胞计数、C反应蛋白等,可以反映患者体内炎症反应的程度[1]。这些指标的变化可以提示医生病情的严重程度,从而制定更合理的治疗方案。
此外,感染指标检测还可以预测病情的发展趋势。通过连续监测患者的感染指标,医生可以了解病情的进展和治疗效果,及时调整治疗方案,提高治疗效果。
二、为什么需要查多个感染指标
在实际临床工作中,医生往往需要检测多个感染指标来综合判断患者的病情。这是因为不同的感染指标具有不同的敏感性和特异性,单一的指标可能无法全面反映患者的病情。具体来说,主要有以下几个原因。
1.不同感染指标的敏感性和特异性不同
不同的感染指标在诊断感染性疾病时具有不同的敏感性和特异性。例如,白细胞计数在细菌感染时往往升高,但在病毒感染时可能正常或下降;而C反应蛋白则在细菌感染和病毒感染时都可能升高。因此,医生需要综合多个指标来判断患者的病情。
2.感染类型的多样性
感染性疾病种类繁多,不同的病原体需要采用不同的治疗方法。单一的指标可能无法涵盖所有类型的感染。例如,某些病原体的特异性抗体在感染后一段时间内才会出现阳性反应,而某些病原体则需要通过核酸检测才能被确诊。因此,医生需要检测多个指标来提高诊断的准确性。
3.病情的复杂性
在实际临床工作中,患者的病情往往比较复杂。有些患者可能同时存在多种感染类型或多种病原体感染;有些患者可能在感染的同时还伴有其他疾病或并发症[2]。在这种情况下,单一的指标可能无法全面反映患者的病情。医生需要综合多个指标来判断患者的病情,并制定相应的治疗方案。
图3 版权图片 不授权转载
三、只查一种感染指标不行吗?
虽然有些感染指标在诊断感染性疾病时具有较高的敏感性和特异性,但只用一种指标来判断患者的病情是不够全面的。因为不同的指标在反映患者病情方面可能存在差异和局限性。正如前文所说,有些病原体的特异性抗体在感染后一段时间内才会出现阳性反应;而有些病原体则需要通过核酸检测才能确诊。如果只依赖一种指标进行判断,可能会导致漏诊或误诊的情况发生。
因此,医生在开具检查项目时,会根据患者的具体情况和需要,综合选择多个指标。这不仅可以提高诊断的准确性,还可以为患者提供更全面、更精准的医疗服务。
四、总结与建议
综上所述,医生在开具检查项目时都是基于医学原则和规范进行的,旨在为患者提供更全面、更准确的诊断服务。同时,我们也应该理解并接受这种检查方式的必要性,积极配合医生进行检查和治疗。同时,我们也应该提高自身的健康意识和医学素养,了解常见感染性疾病的诊断和治疗方法,以便更好地维护自己的健康。
【参考文献】
[1]谈晨,陈炜,张雷,等. 炎性指标对住院严重感染患者病情的评估效果研究[J]. 中华医院感染学杂志,2018,28(22):3378-3380.
[2]沈丽磊,陈国飞. 多种炎症指标联合检测对不同病原菌致脓毒血症的早期诊断价值[J]. 国际检验医学杂志,2023,44(15):1820-1825.

来源: 中华医学会
内容资源由项目单位提供


 科普中国公众号
科普中国公众号
 科普中国微博
科普中国微博

 帮助
帮助
 中华医学会
中华医学会 
